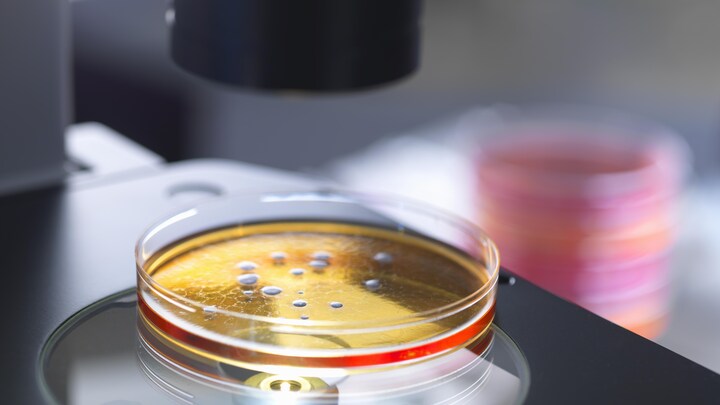

Ny forskning viser, at bakterier kan ændre deres eget DNA unormalt hurtigt.
Det skriver den norske netavis forskning.no.
- Det betyder, at de (bakterierne, red.) hurtigt kan blive resistente over for lægemidler og essentielle vacciner, forklarer én af forskerne bag opdagelsen, Pål Johnsen, der er professor ved Institut for Farmaci på Universitetet i Tromsø i Norge.
Og opdagelsen er banebrydende. Det har nemlig ikke tidligere været muligt at påvise, at bakterier kan mutere og ændre DNA så hurtigt, som man nu har opdaget, fortæller Pål Johnsen.
- Det er helt nyt og ganske banebrydende, siger han.
Bakterierne tilpasser sig miljøet
I forskningsforsøget ville man se, hvordan nutidige bakterier reagerede på at komme i kontakt med en 40.000 år gammel mammut.
Som forventet tog bakterierne mammuttens DNA til sig – men de gjorde det i en uventet høj fart, og det er højst usædvanligt.
DNA er nemlig ikke designet til at skulle ændre sig hurtigt.
- Tænk på hvor langsomt evolution virkelig går. Det skyldes, at der skal meget til for, at DNA'et i vores celler formår at finde DNA-stykker, der passer ind, siger Pål Johnsen.
Man kan sammenligne DNA-mutationer med et puslespil, hvor hvert stykke skal passe sammen.
- Disse puslespilsbrikker er cellernes DNA, siger han.
For at en brik kan erstattes med en anden, så skal brikken normalt være næsten identisk. Men i forsøget opdagede man, at bakterierne meget hurtigt tog mammuttens DNA-stykker til sig for at færdiggøre mutationen, forklarer forskeren.
- Vi er altså snublet over en helt ny mekanisme, siger Pål Johnsen.
Antibiotika kan accelerere udviklingen af antibiotikaresistens
Forskerne bag forsøget gjorde også et interessant fund.
De fandt nemlig ud af at der ved lave koncentrationer af antibiotika, sker DNA-ændringer 600 gange hurtigere end normalt, og det antyder, at nogle former for antibiotika kan påvirke ændringer i vores genmasse.
Altså kan antibiotika accelerere udviklingen af resistens over for antibiotika og muligvis gøre, at vacciner stopper med at virke.
- Godt for bakterierne, men dårligt for os, siger ekspert i molekylær biologi, Klaus Harms, der sammen med Pål Johnsen har skrevet en artikel over deres fund.